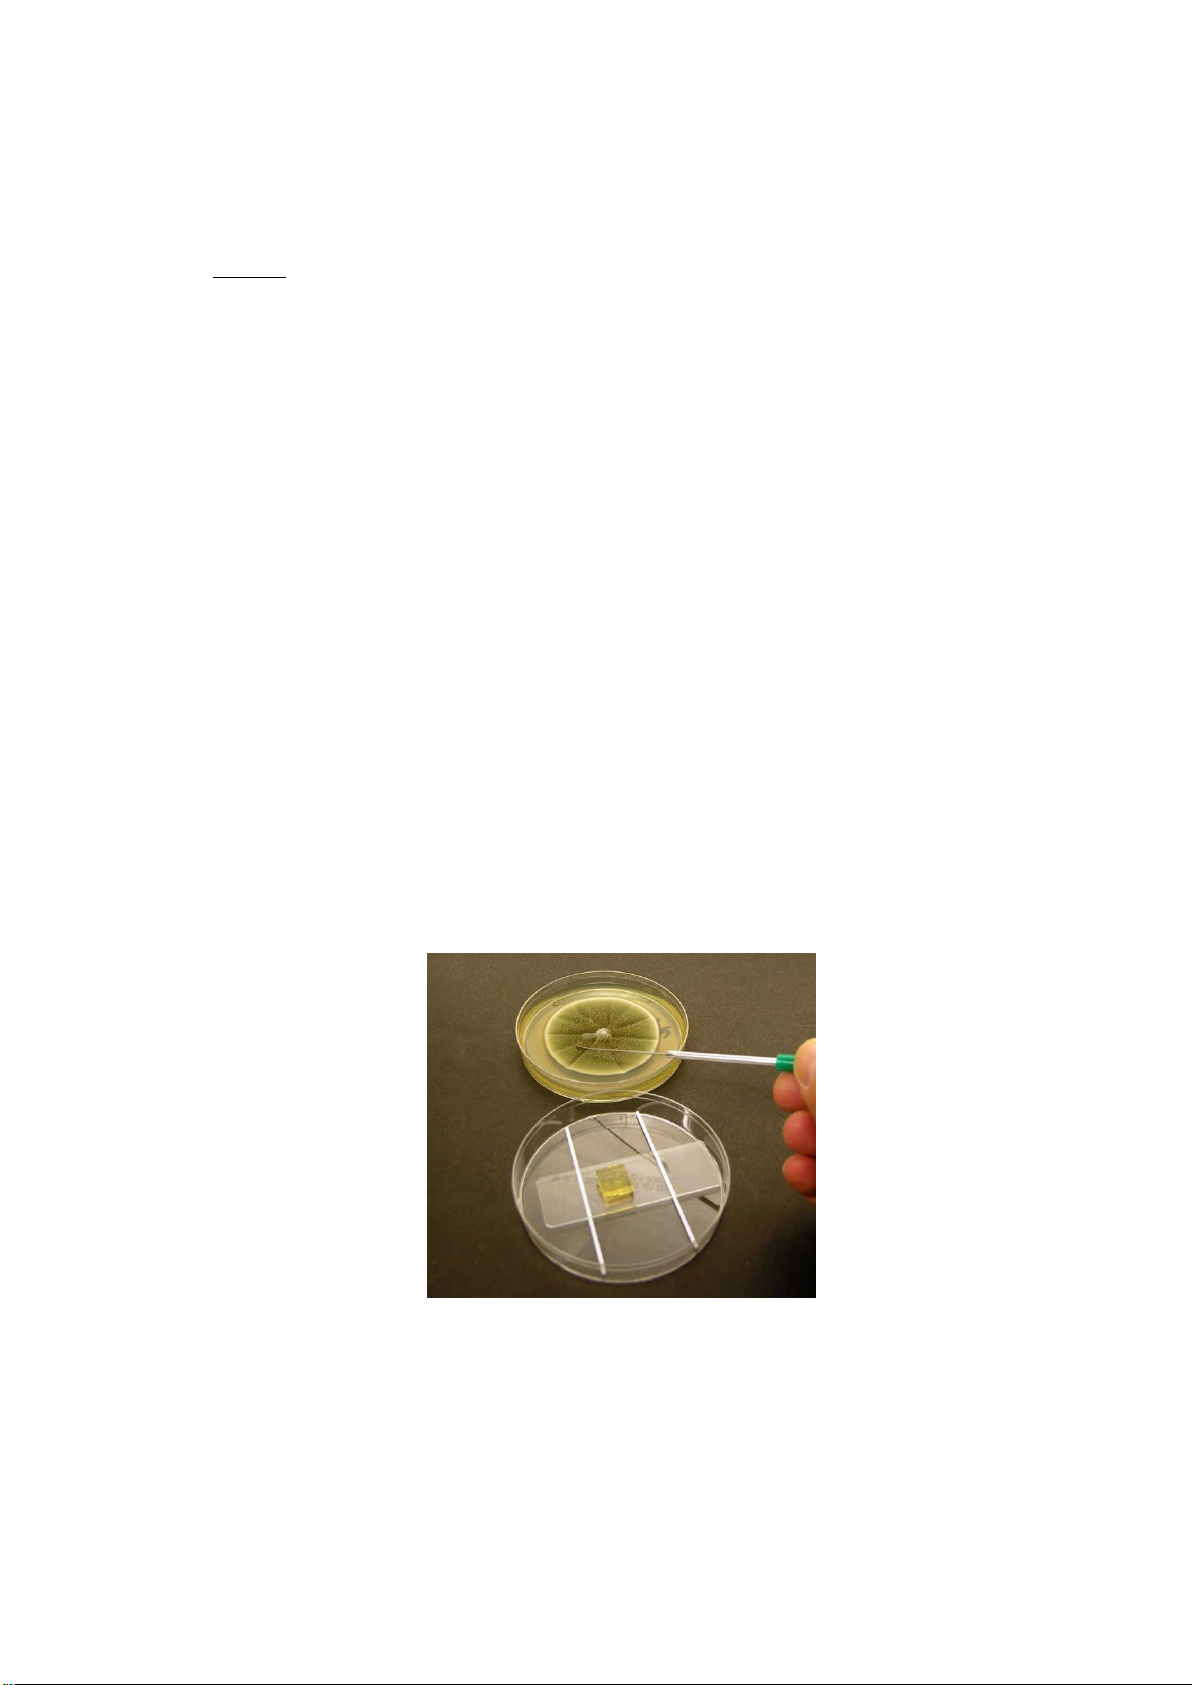

Preview text:
TRƯỜNG ĐẠI HỌC SƯ PHẠM KỸ THUẬT THÀNH PHỐ HỒ CHÍ MINH
KHOA CÔNG NGHỆ HÓA HỌC VÀ THỰC PHẨM ****************
Biên soạn: PGS.TS. TRỊNH KHÁNH SƠN GIÁO TRÌNH
THỰC HÀNH VI SINH VẬT HỌC Lưu hành nội bộ THÀNH PHỐ HỒ CHÍ MINH 01/2022 MỤC LỤC
NỘI QUI PHÒNG THÍ NGHIỆM .............................................................................................. 3
QUAN SAÙT NAÁM SÔÏI .............................................................................................................. 5
ÐÒNH LÖÔÏNG TOÅNG SOÁ VI SINH VẬT HIEÁU KHÍ ............................................................. 11
ÐÒNH LÖÔÏNG TOÅNG SOÁ NAÁM MEN VAØ NAÁM MOÁC ...................................................... 15
ÐÒNH LÖÔÏNG COLIFORMS BAÈNG PHÖÔNG PHAÙP MPN ............................................... 18
PHỤ LỤC 1 MOÄT SOÁ MOÂI TRÖÔØNG THOÂNG DUÏNG ...................................................... 24
PHỤ LỤC 2 CÁCH CHUẨN BỊ MỘT SỐ HÓA CHẤT ........ Error! Bookmark not defined. 2
NỘI QUI PHÒNG THÍ NGHIỆM
Một số sinh vật được sử dụng trong các bài thí nghiệm có thể gây bệnh cho người và
động vật, vì thế các nội qui được ban hành để ngăn ngừa nguy cơ nhiễm bệnh cho sinh viên
và cán bộ phòng thí nghiệm. Bất kỳ cá nhân nào không tuân thủ tốt các nội qui hay gây nguy
hại cho người khác đều không được phép vào phòng thí nghiệm. Khi có bất kỳ thắc mắc nào
phải yêu cầu sự hướng dẫn của giáo viên hoặc cán bộ phòng thí nghiệm.
1. Các qui định chung
Sinh viên vào phòng thí nghiệm phải mặc trang phục bảo hộ (áo khoác trắng) và phải đeo thẻ sinh viên
Sinh viên phải tham dự 100% các buổi thí nghiệm và 100% thời gian trong từng buổi
thí nghiệm. Sinh viên chỉ được phép ra về khi được sử đồng ý của giáo viên.
Sinh viên phải đến đúng giờ, nếu đến trễ quá 15 phút, sinh viên không được phép vào
phòng thí nghiệm và được xem như vắng mặt không lý do
Nếu vì bất kỳ lý do bất khả kháng nào không tham dự được buổi thí nghiệm, sinh viên
phải báo trước (hoặc vào buổi thí nghiệm) cho cán bộ có trách nhiệm
Sinh viên phải hoàn thành đầy đủ các bài thí nghiệm và thực hiện các hình thức kiểm
tra đúng hạn theo yêu cầu của giáo viên.
Khi làm hư hỏng các trang thiết bị của phòng thí nghiệm, sinh viên phải có nghĩa vụ
hoàn trả lại nguyên trạng
Sinh viên phải đọc kỹ bài trước khi vào thí nghiệm và không được mang tài liệu vào phòng thí nghiệm
Khi làm đổ/tràn các dung dịch hoặc làm bể dụng cụ thủy tinh, sinh viên phải báo cáo
cho cán bộ phòng thí nghiệm và xin ý kiến giải quyết
Sinh viên phải nắm vững các thao tác vô trùng: vệ sinh và tiệt trùng (trong autoclave,
121oC/30 phút) tất cả môi truờng, mẫu sinh vật và dụng cụ đã qua thao tác thí nghiệm
Cố gắng giảm thiểu sự hình thành khí dung khi thao tác
Rửa tay trước và sau khi thí nghiệm
Không được ăn/uống trong phòng thí nghiệm
Không được nằm trong phòng thí nghiệm
Đọc kỹ và làm theo các nội qui/qui định trong bài thực hành
Vệ sinh bàn/ghế/kệ…và các dụng cụ trước và sau khi làm thí nghiệm
Đổ bỏ rác thải đúng qui định 3
Không ngậm các đồ dùng (viết, mắt kính…) trong miệng
Trả đầy đủ dụng cụ sau khi hoàn thành xong bài thí nghiệm (dụng cũ đã được tiệt
trùng và rửa sạch)
Vệ sinh phòng thí nghiệm theo yêu cầu của người phụ trách
2. Các yêu cầu an toàn
a. Cột tóc, mặc các trang phục bảo hộ (áo khoác trắng, găng tay chống nhiệt…) và sử
dụng dụng cụ/thiết bị đúng lúc, đúng nơi
b. Nghiêm cấm dùng miệng hút pipette
3. Trong các tình huống khẩn cấp
a. Lưu ý các trang bị cấp cứu khi cần (dụng cụ y tế, bình cứu hỏa, vòi nước, cầu dao điện,
điện thoại và số điện thoại cấp cứu…)
b. Báo cáo các tình huống khẩn cấp ngay lập tức cho giáo viên hướng dẫn hoặc cán bộ trong phòng thí nghiệm
c. Bình tĩnh khi có tình huống khẩn cấp PTN Vi Sinh 4 QUAN SA´T NAÁM SO.I
Kỹ thuật nuôi cấy và quan sát nấm mốc (nấm sợi) hoàn toàn khác so với kỹ thuật
tương ứng dùng cho vi khuẩn. Nấm mốc sinh trưởng tương đối chậm, thường mất khoảng vài
ngày đến vài tuần để phát triển thành khuẩn lạc đủ lớn có thể nhìn thấy được. Khi phát triển,
nấm mốc thường mọc lan trên môi trường. Nấm mốc sẽ tạo thành bào tử (spore) trên các
khuẩn ty khí sinh (aerial phytae) có màu trắng nhạt. Hầu hết nấm mốc phát triển tốt ở 25oC
hơn là ở 35oC. Môi trường cơ bản nhất để nuôi cấy nấm mốc là Sabouraud dextrose agar.
Nồng độ đường cao và pH thấp (5.6) của môi trường này không thích hợp cho sự phát triển
của hầu hết vi khuẩn, do đó đảm bảo hạn chế sự tạp nhiễm. Hầu hết nấm mốc phát triển tốt ở pH 5.6.
Khuẩn lạc nấm mốc có thể được quan sát trực tiếp bằng cách lấy một ít sinh khối và
đặt trên phiến kính (slide) với một giọt nước hay thuốc nhuộm (tương tự tiêu bản giọt ép). Có
một cách khác dùng để quan sát nấm mốc là sử dụng tiêu bản phòng ẩm (slide culture), đây là
tiêu bản có nhiều ưu điểm vì có thể quan sát cấu trúc đặc trưng về hình thái mà không gây ảnh
hưởng gì đến sự phát triển của nấm mốc. Phương pháp này có thể quan sát một cách dễ dàng
các cấu trúc liên quan đến sự sinh sản. Việc định danh nấm mốc thường dựa vào các cấu trúc
liên quan đến sự sinh sản, các đặc tính về hình thái học và sự phát triển của khuẩn lạc.
Cấu trúc đại thể của nấm mốc (khuẩn lạc, colony) thường được gọi là tản (thallus).
Tản là sinh khối của một tập hợp các thành phẩn gọi là hệ sợi (hay còn gọi là khuẩn ty của
nấm mốc, mycelium). Khuẩn ty dinh dưỡng (vegetative hyphae) phát triển trên bề mặt môi
trường và tạo thành khuẩn ty khí sinh gọi là khuẩn ty sinh sản (reproductive hyphae). Khuẩn
ty sinh sản mang bào tử sinh sản (asexual reproductive spore, còn gọi là conidia). Khuẩn ty
phát triển bên dưới bề mặt môi trường được gọi là khuẩn ty dinh dưỡng (rhizoid hyphae hay
rhizoidal hyphae). Sợi nấm có thể có vách ngăn (septum) hoặc không có vách ngăn. Khuẩn ty
có chứa vách ngăn gọi là khuẩn ty có vách ngăn (septate hyphae). Khuẩn ty của nấm mốc có
sợi nấm không có vách ngăn gọi là khuẩn ty không vách ngăn (coenocytic hyphae)
Nấm mốc được phân loại chủ yếu dựa vào các giai đoạn của quá trình sinh sản. Sự phân
loại và các đặc tính của nấm mốc cũng dựa vào đặc điểm của khuẩn lạc (kích thước, màu sắc),
tổ chức của khuẩn ty (có vách ngăn hay không có vách ngăn), cấu trúc và sự tổ chức của bào
tử (sporangiospores-bào tử túi, conidiospores-bào tử đính). Nấm mốc có vai trò quan trọng
trong công nghiệp và là sinh vật phân hủy (decomposer) trong môi trường. Bào tử nấm mốc là
nguồn nhiễm vi sinh vật phổ biến trong các phòng thí nghiệm vi sinh.
Hai giống nấm sợi Aspergillus và Penicillium thuộc lớp nấm bất toàn Deuteromycetes.
Hai giống này không có hình thức sinh sản hữu tính, hệ sợi có vách ngăn, bào tử vô tính là
bào tử trần. Mucor và Rhizophus thuộc lớp nấm tiếp hợp Zygomycetes. Hai giống này không
có vách ngăn và có thể có rễ giả, bào tử vô tính là bào tử kín, bào tử hữu tính là bào tử tiếp
hợp. Rhizopus có cuống mang bào tử và không phân nhánh. Mucor có cuống mang bào tử phân nhán. 5
Hình 1. Cấu trúc và sự tổ chức của bào tử ở nấm mốc
Hình 2. Aspergillus niger 6
Hình 3. Aspergillus nidulans
Hình 4. Hình dạng một số loại nấm mốc
Saptate hyphae (Penicillium) – mỗi khoang
Non-Septate Hyphae (Coenocytic hyphae) là một tế bào
Hình 5. Sợi nấm có vách ngăn và không có vách ngăn
Qui trình quan sát hình thái nấm mốc
Quan sa´t hình tha´i khuaån la.c, ma`u saéc s6.i naám treˆn hoˆp petri.
Cho một giọt methylen blue (0.3% trong ethanol) vào phiến kính hình chữ nhật.
Dùng que cấy móc (vô trùng) lấy một ít hệ sợi nấm mốc đặt nhẹ nhàng lên giọt methylen blue.
Quan sa´t dn6´i kính hieån vi
Qui trình chuẩn bị tiêu bàn phòng ẩm
Chuẩn bị các phiến kính hình chữ nhật (glass slide) và phiến kính hình vuông
(coverslips). Ngâm phiến kính trong ethanol 80% trong tối thiểu 15 phút (hình 5).
Hơ bề mặt của các phiến kính này trên ngọn lửa để vô trùng (dùng kẹp để cầm). Cách 1:
Dùng mũi dao (đã vô trùng trên ngọn lửa đèn cồn, sau đó chờ nguội), cắt một mảnh
môi trường Sabouraund dextrose agar hay Potato dextrose agar (vô trùng, đã chuẩn bị
sẵn trên đĩa petri) có kích thước 11cm đặt vào chính giữa phiến kính hình chữ nhật. 8
Dùng que cấy móc, bằng thao tác vô trùng, lấy một ít hệ sợi nấm mốc đặt vào giữa
mảnh môi trường. Sau đó, đặt phiến kính hình vuông lên mảnh môi trường (phiến kính
hình vuông đã ngâm trong ethanol 80% trong 15 phút, dùng kẹp lấy ra đặt trên giấy
thấm vô trùng trong đĩa petri để tự khô). Cách 2:
Dùng parafin làm thành hai đường kẻ ngang phiến kính hình chữ nhật (hình 6) làm sao
để bề mặt phiến kính hình vuông cách bề mặt phiến kính hình chữ nhật 1mm.
Đun chảy ống nghiệm chứa môi trường Sabouraund dextrose agar hay Potato dextrose
agar, sau đó làm nguội đến 48 – 50oC
Dùng pipette vô trùng chuyển 0.5 ml huyền phù nấm mốc vào ống nghiệm chứa các môi trường trên.
Nhanh chóng chuyển hỗn hợp này vào khoảng giữa hai phiến kính sao cho chiếm
khoảng một nữa khoảng trống giữa hai phiến kính (hình 6). Các bước trên phải tiến
hành thật nhanh trước khi môi trường đông đặc lại (phiến kính hình vuông đã ngâm
trong ethanol 80% trong 15 phút, dùng kẹp lấy ra đặt trên giấy thấm vô trùng trong đĩa petri để tự khô).
Sau khi thực hiện một trong hai cách trên, tiếp tục tiến hành như sau:
Cho một ít giấy thấm nước (vô trùng) vào đĩa petri. Cho một vài que tăm vào bên trên
phần giấy thấm. Đặt các phiến kính vừa chuẩn bị ở phần trước lên trên các que tăm. Ủ
ở nhiệt độ phòng từ 1 – 2 ngày (sao cho nấm mốc vừa chớm sinh bào tử) (hình 6d).
Quan sát dưới kính hiển vi với vật kính từ 4 đến 40. Lưu ý: có thể dùng dung dịch
methylen blue (0.3% trong ethanol) để nhuộm màu giúp quan sát rõ hơn cấu trúc của
nấm mốc (cồn giúp làm mềm vách tế bào nấm mốc giúp thuốc nhuộm dễ đi vào tế bào hơn).
Hình 6. Tiêu bàn phòng ẩm để quan sát nấm mốc (cách 1) 9
Hình 7. Qui trình chuẩn bi tiêu bàn phòng ẩm để quan sát nấm mốc (cách 2) 10
бNH LPO.NG TOÅNG SOÁ VI SINH VẬT HIEÁU KHÍ
1 Ðịnh nghĩa vaø nguyeˆn taéc
Vi khuaån hieáu khí la` nhn˜ng vi khuaån taêng trn6´ng va` hình tha`nh khuaån la.c trong đie“u
kieˆn co´ sn. hieˆn dieˆn cu´a oxi phaˆn tn´. Toång soá vi khuaån hieáu khí hieˆn dieˆn trong ma"u chĩ
thị mn´c đoˆ veˆ sinh cu´a thn.c phaåm. Chĩ soá na`y đn6.c xa´c định baèng phn6ng pha´p đeám
khuaån la.c mo.c treˆn moˆi trn6`ng tha.ch dinh dn6˜ng trong moˆt ln6.ng ma"u xa´c định treˆn c6 s6´
xem 1 khuaån la.c la` sinh khoái pha´t trieån tn` moˆt teá ba`o hieˆn dieˆn trong ma"u va` đn6.c bieåu
die"n dn6´i da.ng moˆt đ6n vị hình tha`nh khuaån la.c (Colony Forming Unit, CFU), trong 1 đ6n
vị khoái ln6.ng thn.c phaåm. Chĩ soá na`y co´ moˆt soá teˆn go.i kha´c nhau nhn sau: soá vi sinh vaˆt
hieáu khí (Aerobic Plate Count, APC), toång soá đeám treˆn đĩa (TotalViable Count, TPC), toång
soá vi sinh vaˆt soáng (Total Viable Count, TVC), soá đeám đĩa chuaån (Standard Plate Count, SPC)
Qui trình phaˆn tích bao go“m ca´c bn6´c caˆn ma"u, đo“ng nhaát ma"u, pha loa˜ng tha`nh ca´c
da˜y no“ng đoˆ thaˆp phaˆn, chuyeån va` phaˆn phoái đe“u moˆt theå tích xa´c định ma"u leˆn treˆn be“
maët moˆi trn6`ng raén trong đĩa petri baèng phn6ng pha´p tra˜i hoˆp (spread plate) hay đoå hoˆp
(pour plate). U´ 6´ đie“u kieˆn nhieˆt đoˆ va` th6`i gian qui định. Phn6ng pha´p đoå hoˆp đn6.c sn´
du.ng phoå bieán trong ca´c pho`ng kieåm nghieˆm vi sinh.
Ðie“u kieˆn nhieˆt đoˆ va` th6`i gian u´ thay đoåi tu`y theo yeˆu ca“u phaˆn tích va` qui định cu´a
tn`ng quoác gia. Chĩ tieˆu toång soá vi sinh vaˆt hieáu khí đn6.c du`ng đeå đa´nh gia´ chaát ln6.ng cu´a
ma"u ve“ vi sinh vaˆt, nguy c6 hn ho´ng, th6`i ha.n ba´o qua´n cu´a sa´n phaåm, mn´c đoˆ veˆ sinh
trong qua´ trình cheá bieán, ba´o qua´n sa´n phaåm. 11
2 Moˆi trn6øng vaø ho´a chaát
Moˆi trn6`ng sn´ du.ng la` Plate Count Agar (PCA) co´ pH 7.0 ± 0.2. Moˆi trn6`ng đn6.c pha
cheá, phaˆn phoái va`o ca´c bình thu´y tinh va` haáp tieˆt tru`ng 6´ 121oC trong 15 phu´t. Ca´c bình
hoaëc oáng nghieˆm chn´a moˆi trn6`ng chna sn´ du.ng pha´i đn6.c ba´o qua´n trong tu´ la.nh 2 – 8oC.
Trn6´c khi sn´ du.ng pha´i đn6.c đun cha´y va` la`m nguoˆi khoa´ng 45 - 50oC trong beå đie“u nhieˆt.
Nn6´c caát đn6.c chn´a trong ca´c bình thu´y tinh va` tieˆt tru`ng 6´ 121oC trong 15 phu´t. Sau
đo´ pha´i đn6.c ba´o qua´n trong tu´ la.nh 2 – 8oC.
3 Qui trình phaˆn tích (maãu da.ng lo´ng) 3.1.
Chuaån bị maãu trn6´c khi phaˆn tích
Ma"u đn6.c pha loa˜ng theo da˜y thaˆp phaˆn (hình 7) baèng ca´ch du`ng pipette voˆ tru`ng
chuyeån 0.1 ml ma"u va`o eppendorf chn´a 0.9 ml nn6´c voˆ tru`ng (hoặc dung dịch nước muối
sinh lý 0.9% NaCl, hoặc dung dịch 0.1% pepton). Troˆn ma"u thaˆt ky˜ baèng ma´y troˆn oáng
nghieˆm. Dung dịch na`y co´ đoˆ pha loa˜ng 10-1. Tieáp tu.c chuyeån 0.1 ml ma"u tn` đoˆ pha loa˜ng
10-1 sang oáng nghieˆm chn´a 0.9 ml nn6´c voˆ tru`ng thn´ 2. Troˆn ma"u thaˆt ky˜. Dung dịch na`y
co´ đoˆ pha loa˜ng 10-2. Tieáp tu.c tieán ha`nh tn6ng tn. đeå co´ ca´c đoˆ pha loa˜ng 10-3, 10-4...(Co´
theå sn´ du.ng ca´c eppendorf, loa.i 2 ml, chn´a saün 1350 l nn6´c voˆ tru`ng đeå pha loa˜ng 150 l
ma"u đeå co´ keát qua´ pha loa˜ng thaˆp phaˆn tn6ng tn. nhn treˆn; hoaëc cu˜ng co´ theå du`ng oáng
nghieˆm đeå thn.c hieˆn v6´i theå tích l6´n h6n). Lnu y´:
Ða“u tip cu´a pipette co´ nguy c6 bị nhie"m trong qua´ trình thao ta´c (cha.m tay,
cha.m maët ngoa`i oáng nghieˆm, maët ngoa`i bình chn´a…), ca“n pha´i thay đa“u tip voˆ tru`ng kha´c.
Ca´c thao ta´c tieán ha`nh trong đie“u kieˆn voˆ tru`ng (sn´ du.ng đe`n co“n)
Ca´c du.ng cu. (pipette, đa“u tip, đĩa petri…) pha´i đn6.c tieˆt tru`ng trn6´c khi sn´
du.ng (tieˆt tru`ng trong autoclave 121oC/30 phu´t hoaëc saáy 6´ 150oC/3 gi6`) 12 0.1 ml 0.9 ml dung dịch pepton 10-1 10-2 10-3 n
Hình 8. Phương pháp pha loãng mẫu 3.2. Ðoå dĩa
a. Du`ng bu´t loˆng da“u ghi chu´ leˆn maët dn6´i cu´a đĩa petri (teˆn ma"u, nga`y tieán ha`nh, đoˆ
pha loa˜ng, nho´m nghieˆn cn´u…) (hình 8)
b. Du`ng pipette voˆ tru`ng chuyeån 0.1 ml (hoaëc 1 ml) dịch ma"u pha loa˜ng va`o gin˜a đĩa
petri. Tn6ng n´ng v6´i mo"i đoˆ pha loa˜ng thn.c hieˆn ít nhaát 2 – 3 đĩa (tn´c la` 2 – 3 la“n laëp la.i).
c. Sau khi caáy, đoå va`o mo"i đĩa 10 – 15 ml moˆi trn6`ng PCA đa˜ đn6.c đun cha´y va` oån định 6´ 45 - 50oC.
d. Troˆn đe“u dịch ma"u v6´i moˆi trn6`ng baèng ca´ch xoay tro`n đĩa petri xuoˆi va` ngn6.c
chie“u kim đo“ng ho“, mo"i chie“u 3 – 5 la“n ngay sau khi đoå moˆi trn6`ng.
e. Ðaët ca´c đĩa treˆn maët phaúng ngang va` đeå yeˆn cho moˆi trn6`ng đoˆng đaëc hoa`n toa`n (khoa´ng 15 phu´t).
f. U´ trong tu´ aám 6´ nhieˆt đoˆ 30oC trong 24 – 48 gi6` (24 gi6` laáy keát qua´ s6 boˆ, 48 gi6`
laáy keát qua´ chính thn´c)
Löu yù: khi uû phaûi ñeå hoäp petri ôû tra.ng thaùi laät uùp (phaàn moâi truôøng ôû treân, phaàn naép naèm beân duôùi)
Ca´ch tính keát qua´
Trường hợp số khuẩn lạc trên các đĩa petri nằm trong khoảng 25-250 CFU (một số
tài liệu khác yêu cầu số khuẩn lạc trên mỗi đĩa phải nằm trong khoảng 30-300 CFU) 13 ∑ N = 1 × 1 + 0.1 × 2 × Trong đó:
N: số khuẩn lạc trên 0.1 ml mẫu (nếu cho 1 ml mẫu vào mỗi đĩa petri thì N là số khuẩn
lạc trên 1 ml mẫu, Thể tích mẫu cho vào đĩa nằm phải nằm trong khoảng 0.1-1 ml). N
trình bày dưới dạng một chữ số gồm 1 số ở hàng đơn vị và một chữ số ở hàng thập
phân cùng với 10n (ví dụ: 2.4×104).
∑C: tổng số khuẩn lạc trên tất cả các đĩa được đếm (các đĩa có 25-250 CFU)
n1: số đĩa của độ pha loãng đầu tiên
n2: số đĩa của độ pha loãng kế tiếp
d: độ pha loãng của các đĩa đầu tiên (10-n) Ví dụ: Độ pha loãng 10-2 10-3
Số khuẩn lạc (CFU) trên các đĩa 232; 244 33; 28
Giá trị APC (aerobic plate count) được tính như sau: (232+244+33+28) N = 1×2 +(0.1×2) ×10−2
= 537/0.022 = 24 409 = 2.4×104 CFU/0.1 ml = 2.4×105 CFU/ml
Trường hợp số khuẩn lạc trên tất cả đĩa petri <25 CFU (trường hợp cho 1 ml mẫu lên đĩa petri) Ví dụ: Độ pha loãng 10-2 10-3 EAPC/ml (hoặc EAPC/g)
Số khuẩn lạc (CFU) 18; 0 2; 0 < 2 500 trên các đĩa
EAPC: số khuẩn lạc ước tính (estimated aerobic plate count)
Trường hợp số khuẩn lạc trên tất cả đĩa petri >250 CFU (trường hợp cho 1 ml mẫu lên đĩa petri) Độ pha loãng 10-2 10-3 EAPC/ml (hoặc EAPC/g)
Số khuẩn lạc (CFU) TNTC 640 640 000 trên các đĩa
TNTC: quá nhiều để có thể đếm được (too numerous to count)
Tất cả các đĩa đều có khuẩn lạc mọc lan hay có các sự cố bất ngờ xảy ra trong quá
trình thực hiện sẽ được ghi nhận kết quả là SPR (mọc lan, spreader) hay LA (sự cố
kỹ thuật, laboratory accident).
Tất cả các đĩa có trung bình số khuẩn lạc >100 CFU/cm2 (trường hợp cho 1 ml mẫu lên đĩa petri) Độ pha loãng 10-2 10-3 EAPC/ml (hoặc EAPC/g)
Số khuẩn lạc (CFU) TNTC 7 150(a) >6 500 000 trên các đĩa TNTC 6 490(b) >5 900 000
aDiện tích bề mặt đĩa là 65 cm2; bDiện tích bề mặt đĩa là 59 cm2 14
бNH LPO.NG TOÅNG SOÁ NAÁM MEN VAØ NAÁM MOÁC
1. Ðịnh nghĩa vaø nguyeˆn taéc
Naám men va` naám moác la` nho´m vi sinh vaˆt raát đa da.ng, cho đeán nay co´ h6n 4 traêm
nga`n loa`i naám men va` naám moác đa˜ đn6.c moˆ ta´. Chu´ng thuoˆc nho´m Eucaryote, co´ va´ch teá
ba`o la` l6´p vo´ chitin. Naám men va` naám moác la` ca´c vi sinh vaˆt dị dn6˜ng, chu´ng tieˆu thu.
nguo“n carbon hn˜u c6 đn6.c cung caáp tn` moˆi trn6`ng beˆn ngoa`i teá ba`o.
Ha“u heát naám moác va` naám men thuoˆc nho´m mesophiles, moˆt soá ít thuoˆc nho´m
psychrophiles, hoaëc thermophiles. Ha“u heát naám men va` naám moác pha´t trieån trong moˆi
trn6`ng co´ hoa.t đoˆ nn6´c tn` 85% tr6´ leˆn, moˆt soá ít loa`i co´ theå taêng trn6´ng trong moˆi trn6`ng
co´ hoa.t đoˆ nn6´c 60 – 70%. Naám moác va` naám men taêng trn6´ng đn6.c trong khoa´ng pH tn`
2.0 – 9.0, trong đo´ pH thích h6.p nhaát la` 4.0 – 6.5. Ða soá naám men va` naám moác đe“u thuoˆc
nho´m hieáu khí baét buoˆc, moˆt soá co´ theå pha´t trieån trong đie“u kieˆn vi hieáu khí. Moˆt soá loa`i
co´ theå tieáp nhaˆn oxi nguyeˆn tn´ tn` c6 chaát, nhnng du` 6´ da.ng na`o, oxi va"n la` nguyeˆn toá ca“n
thieát cho qua´ trình pha´t trieån cu´a naám moác va` naám men.
Trong thn.c phaåm, sn. hieˆn dieˆn va` sinh trn6´ng cu´a chu´ng co´ theå la`m thay đoåi ca´c tính
chaát cu´a thn.c phaåm (ma`u saéc, mu`i vị…), gaˆy hn ho´ng va` co´ theå ta.o tha`nh moˆt soá đoˆc toá
gaˆy ngoˆ đoˆc thn.c phaåm.
Maˆt đoˆ naám moác va` naám men trong ma"u đn6.c xa´c định chung dn6´i da.ng toång soá naám
men va` naám moác baèng ca´c ky˜ thuaˆt pha loa˜ng, tra´i đĩa va` đeám khuaån la.c treˆn moˆi trn6`ng
Dichloran Glycerol Agar, hay Dichloran Rose Bengal Chloramphenicol Agar (DRBC). Moˆi
trn6`ng Dichloran Glycerol Agar đn6.c sn´ du.ng cho ca´c loa.i thn.c phaåm co´ ha`m ln6.ng nn6´c
thaáp (thn.c phaåm khoˆ, ngu˜ coác, tieˆu…, ca´c loa.i thn.c phaåm co´ da“u, co´ ha`m ln6.ng
đn6`ng/muoái cao). Moˆi trn6`ng DRBC đn6.c sn´ du.ng cho ca´c ma"u co´ ha`m ln6.ng nn6´c cao
(sn˜a, ca´c sa´n phaåm tn` sn˜a, đo“ hoˆp, ca´c loa.i rau qua´…). Ðoái v6´i ca´c ma"u co´ maˆt đoˆ naám
moác thaáp, ca´c moˆi trn6`ng thn6`ng đn6.c sn´ du.ng la` Malt Extract Agar (MEA), Potato
Dextrose Agar (PDA) chn´a 40 ppm (0.004%) chloramphenicol (hay chlortetraciline) va` 0.0084g/L rose bengal. 15 Ghi chuù:
Cho moät vieân chloramphenicol 250 mg pha vaøo 10ml nuôùc caát, laéc ñeàu, ñeå laéng caën. Boå
sung 1.6 ml dung dịch naøy vaøo moâi truôøng PDA roài ñịnh muùc veà 1000 ml ñeå coù noàng ñoä
40 ppm chloramphenicol.
Pha dung dịch rose bengal 0.1% (0.1g rose bengal trong 100 ml nuôùc caát). Duøng 8.4 ml
dung dịch naøy cho vaøo moâi truôøng chloramphenicol-PDA roài ñịnh muùc veà 1000 ml
2. Ca´ch tieán haønh
a. Tieán ha`nh pha loa˜ng thaˆp phaˆn ma"u ban đa“u
b. Sn´ du.ng ky˜ thuaˆt tra´i đĩa đeå tieán ha`nh xa´c định chĩ tieˆu toång soá naám men, naám moác trong ma"u (hình 8)
Ghi nha˜n leˆn maët sau đĩa petri (teˆn ma"u, teˆn ky˜ thuaˆt vieˆn, nga`y…)
Ðoå moˆi trn6`ng agar (no´ng cha´y) va`o trong đĩa petri (khoa´ng 15ml). Ch6` cho
moˆi trn6`ng đoˆng đaëc hoa`n toa`n (khoa´ng 15 phu´t)
Du`ng pipette cho 0.1 ml ma"u va`o chính gin˜a đĩa tha.ch
Nhu´ng que trang thu´y tinh (hình L) va`o moˆt coác chn´a ethanol. Sau đo´ go˜
nhe. que thu´y tinh va`o tha`nh coác đeå loa.i b6´t ethanol thn`a
Khe˜ đna que thu´y tinh ga“n ngo.n ln´a đe`n ethanol đeå la`m boác cha´y que thu´y
tinh. La`m nguoˆi baèng ca´ch cha.m que thu´y tinh va`o pha“n naép beˆn trong đĩa tha.ch.
Tra´i ma"u vi sinh vaˆt sao cho ma"u da`n đe“u khaép be“ maët moˆi trn6`ng tha.ch.
Nhu´ng que thu´y tinh va`o ethanol, go˜ nhe. va`o coác va` đoát cha´y que thu´y tinh.
Laëp la.i thao ta´c v6´i đĩa tha.ch keá tieáp. Tn6ng n´ng v6´i mo"i đoˆ pha loa˜ng thn.c
hieˆn ít nhaát 2 – 3 đĩa (tn´c la` 2 – 3 la“n laëp la.i).
Tieán ha`nh nuoˆi caáy trong tu´ u´ vi sinh 6´ 30oC trong 16-24 gi6` (sao cho khuaån
la.c naám moác vn`a ch6´m ta.o tha`nh va` chna co´ sn. hình tha`nh ba`o tn´)
Tieán ha`nh quan sa´t hình tha´i đa.i theå cu´a khuaån la.c, đeám soá khuaån la.c naám
men/naám moác va` ghi nhaˆn la.i keát qua´. 3. Ðo.c keát qua´
a. Tn6ng tn. ba`i “Ðịnh ln6.ng toång soá vi khuaån hieáu khí” 16
b. Ðo.c keát qua´ ca´c đĩa co´ tn` 10 – 150 colonies (tạm dịch là khuẩn lạc nấm mốc hoặc
khuẩn lạc nấm men) sau nga`y 16 đeán 24 gi6` nuoˆi caáy.
Löu yù: trong thôøi gian uû, naám moác coù theå ta.o baøo tuû vaø phaùt taùn vaøo trong moâi
truôøng nuoâi caáy, ta.o thaønh khuaån la.c môùi. Ðeå ha.n cheá hieän tuô.ng naøy, trong suoát
thôøi gian uû, hạn chế cha.m tay hoaëc di chuyeån caùc ñĩa cho ñeán khi ñeám keát quaû. Maët
khaùc, khi tieán haønh ñeám khuaån la.c caàn ha.n cheá vieäc môû ñĩa ñeå traùnh su. phaùt taùn cuûa
baøo tuû vaøo khoâng khí, gaây nhieãm vaøo maãu hay moâi truôøng nuoâi caáy khaùc. Caùc ñĩa
khi ñem uû phaûi ñeå maët chuùa moâi truôøng naèm phía duôùi, naép ñĩa petri naèm treân.
Hình 9. Ky˜ thuaˆt đoå đĩa va` tra˜i đĩa 17
бNH LPO.NG COLIFORMS BA“NG PHPONG PHA´P MPN 1.
Ðịnh nghĩa Coliforms, Coliforms chịu nhieˆt, Coliforms phaˆn
Coliforms (hình 9) la` nhn˜ng trn.c khuaån gram aˆm khoˆng sinh ba`o tn´, hieáu khí hoaëc kị
khí tu`y y´, co´ kha´ naêng leˆn men lactose sinh acid va` sinh h6i 6´ 37oC trong 24 – 48 gi6`.
Trong thn.c teá phaˆn tích, Coliforms co`n đn6.c định nghĩa la` ca´c vi khuaån co´ kha´ naêng leˆn
men sinh h6i trong khoa´ng 48 gi6` khi đn6.c u´ 6´ 37oC trong moˆi trn6`ng lo´ng Lauryl Sulfate
va` moˆi trn6`ng Brilliant Green Lactose Bile Salt. Nho´m Coliforms hieˆn dieˆn roˆng ra˜i trong
tn. nhieˆn, trong ruoˆt ngn6`i va` đoˆng vaˆt. Coliforms đn6.c xem la` nho´m vi sinh vaˆt chĩ thị: soá
ln6.ng hieˆn dieˆn cu´a chu´ng trong thn.c phaåm, nn6´c hay co´ loa.i moˆi trn6`ng đn6.c du`ng đeå
chĩ thị kha´ naêng hieˆn dieˆn cu´a ca´c vi sinh vaˆt gaˆy beˆnh kha´c. Nhie“u nghieˆn cn´u cho thaáy
raèng khi soá Coliforms cu´a thn.c phaåm cao thì kha´ naêng hieˆn dieˆn cu´a ca´c vi sinh vaˆt gaˆy
beˆnh kha´c cu˜ng cao. Tuy nhieˆn, moái lieˆn heˆ gin˜a vi sinh vaˆt gaˆy beˆnh va` vi sinh vaˆt chĩ
thị na`y va"n co`n nhie“u tranh ca˜i. Nho´m Coliforms go“m 4 gioáng: Escherichia v6´i 1 loa.i duy
nhaát la` E.coli, Citrobacter, Clebsiella, Enterobacter. Tính chaát sinh hoa´ đaëc trnng cu´a
nho´m na`y đn6.c theå hieˆn qua ca´c thn´ nghieˆm indol (I), Methy Red (MR), Voges-Proskauer
(VP) va` Citrate (iC) thn6`ng đn6.c go.i to´m taét chung la` IMViC.
Coliforms chịu nhieˆt la` nhn˜ng Coliforms co´ kha´ naêng leˆn men lactose sinh h6i trong
khoa´ng 24 gi6` khi u´ 6´ 44oC trong moˆi trn6`ng lo´ng EC. Coliforms phaˆn (faecal coliforms
hay E.coli gia´ định)la` Coliforms chịu nhieˆt co´ kha´ naêng sinh indole khi đn6.c u´ khoa´ng 24
gi6` 6´ 44.5oC trong moˆi trn6`ng lo´ng Trypton. Coliforms phaˆn la` moˆt tha`nh pha“n cu´a heˆ vi
sinh đn6`ng ruoˆt 6´ ngn6`i va` đoˆng vaˆt ma´u no´ng kha´c va` đn6.c sn´ du.ng đeå chĩ thị mn´c đoˆ veˆ
sinh trong qua´ trình cheá bieán, ba´o qua´n, vaˆn chuyeån, thn.c phaåm, nn6´c uoáng cu˜ng nhn đeå
chĩ thị sn. oˆ nhie"m phaˆn trong ma"u moˆi trn6`ng. E.coli la` Coliforms phaˆn cho keát qua´ thn´
nghieˆm IMViC la` ++-- (Indol + , Methyl Red + , Voges-Proskauer -, Citrate -) 18
Hình 10. Coliform toång soá 2.
Phn6ng pha´p MPN (Most Probable Number)
Phn6ng pha´p MPN (phn6ng pha´p soá co´ xa´c suaát cao nhaát, soá toái kha´) co`n đn6.c go.i la`
phn6ng pha´p pha loa˜ng t6´i ha.n hay phn6ng pha´p chuaån đoˆ. Ðaˆy la` phn6ng pha´p du`ng đeå
đa´nh gia´ soá ln6.ng vi sinh vaˆt theo soá ln6.ng vi sinh vaˆt co´ xa´c suaát l6´n nhaát hieˆn dieˆn trong
moˆt đ6n vị theå tích ma"u. Ðaˆy la` phn6ng pha´p định ln6.ng dn.a treˆn keát qua´ định tính cu´a
moˆt loa.t thí nghieˆm đn6.c laëp la.i 6´ moˆt soá đoˆ pha loa˜ng kha´c nhau. Thoˆng thn6`ng, vieˆc
định ln6.ng na`y đn6.c thn.c hieˆn laëp la.i 6´ 3 la“n đoˆ pha loa˜ng baˆc 10 lieˆn tieáp, toång coˆng 3 x 3 = 9 oáng nghieˆm.
Qui trình thn.c hieˆn định ln6.ng theo phn6ng pha´p na`y la` nhn sau: cho va`o oáng nghieˆm
co´ chn´a moˆi trn6`ng thích h6.p cho sn. taêng trn6´ng cu´a đoái tn6.ng vi sinh vaˆt ca“n định ln6.ng
moˆt theå tích chính xa´c dung dịch ma"u 6´ 3 no“ng đoˆ pha loa˜ng baˆc 10 lieˆn tieáp (ví du. 10-1,
10-2, 10-3). U´ 6´ nhieˆt đoˆ va` th6`i gian thích h6.p. Dn.a va`o keát qua´ bieåu kieán chn´ng minh sn.
taêng trn6´ng cu´a vi sinh vaˆt ca“n kieåm định trong tn`ng oáng nghieˆm (thn6`ng la` ca´c hieˆn
tn6.ng sinh h6i, đoåi ma`u, đu.c…). Ghi nhaˆn soá ln6.ng ca´c oˆng nghieˆm dn6ng tính 6´ tn`ng đoˆ
pha loa˜ng. Sn´ du.ng ca´c soá lieˆu na`y va` dn.a va`o ba´ng Mac Crady suy ra maˆt đoˆ vi sinh vaˆt
đn6.c trình ba`y dn6´i da.ng soá MPN/ml, MPN/ g ma"u (soá vi sinh vaˆt/ml hay soá vi sinh vaˆt/g
ma"u). Ðoˆ chính xa´c cu´a trị soá MPN phu. thuoˆc va`o soá ln6.ng oáng nghieˆm laëp la.i trong mo"i
đoˆ pha loa˜ng: soá ln6.ng oáng nghieˆm laëp la.i ca`ng cao thì đoˆ chính xa´c cu´a trị soá vi sinh vaˆt
co´ theå đn6.c nuoˆi caáy trong moˆi trn6`ng lo´ng cho.n lo.c va` cho keát qua´ bieåu kieán thích h6.p.
Ví du., sn´ du.ng moˆi trn6`ng BGBL 6´ 37oC co´ theå định ln6.ng nho´m coliforms, cu`ng moˆi
trn6`ng na`y 6´ 45oC cho phe´p định ln6.ng Coliforms phaˆn hoaëc moˆi trn6`ng Mannitol Salt
Broth co´ theå du`ng đeå định ln6.ng Staphylococcus… 3.
Ðịnh ln6.ng Coliforms ba“ng phn6ng pha´p MPN
a. Tua“n tn. caáy 1 ml dịch ma"u đa˜ pha loa˜ng 10-1 va`o 3 oáng nghieˆm gioáng nhau, mo"i oáng
chn´a moˆi trn6`ng LSB va` oáng Durham u´p ngn6.c (ln6.ng moˆi trn6`ng pha´i vn6.t qua´ chie“u
cao oáng Durham). Thn.c hieˆn tn6ng tn. v6´i dịch ma"u đa˜ pha loa˜ng 10-2, 10-3 đeán 10-10…U´
oáng nghieˆm trong 48 gi6` 6´ 37oC. Oáng dn6ng tính la` oáng co´ sinh khí (bo.t khí trong oáng
Durham). Ghi nhaˆn soá oáng dn6ng tính.
b. Thn´ nghieˆm khaúng định: du`ng que caáy vo`ng chuyeån dịch ma"u tn` ca´c oáng LSB dn6ng
tính sang ca´c oáng chn´a moˆi trn6`ng BGBL va` u´ 6´ 37oC trong 48 gi6`. Ghi nhaˆn soá oáng
dn6ng tính n´ng v6´i mo"i đoˆ pha loa˜ng
Löu yù: caàn loa.i boû (tieät truøng truôùc khi loa.i boû) caùc oáng nghieäm coù chuùa vi sinh vaät
sau khi ñaõ laøm thí nghieäm xong. Caùc oáng coù khaû naêng hieän dieän cuûa Coliforms laø
caùc oáng duông tính ôû caû moâi truôøng LSB laãn BGBL. 4.
Ln.a cho.n ca´c doˆ pha loa˜ng deå tính keát qua´
Khi nhieàu hôn 3 ñoä pha loaõng đn6.c thieát laˆp trong phe´p đo, keát qua´ cu´a 3 đoˆ pha
loa˜ng se˜ đn6.c cho.n đeå xa´c định gia´ trị MPN. Cho.n ñoä pha loaõng thaáp nhaát (heˆ soá pha
loa˜ng cao nhaát) co´ caû 3 oáng duông tính cu`ng v6´i 2 oáng co´ đoˆ pha loa˜ng thaáp h6n tieáp
theo (heˆ soá pha loa˜ng cao h6n tieáp theo) (ví du. a, b, c, d, e, f).
Khi đoˆ pha loa˜ng thaáp h6n 3 đoˆ pha loa˜ng đa˜ đn6.c cho.n 6´ treˆn xuaát hieˆn 1 oáng
dn6ng tính, thì 1 oáng dn6ng tính na`y se˜ đn6.c tính theˆm va`o đoˆ pha loa˜ng thaáp nhaát
trong 3 đoˆ pha loa˜ng đa˜ đn6.c cho.n 6´ treˆn (ví du. g, h)
Neáu khoˆng co´ baát ky` đoˆ pha loa˜ng na`o trong da˜y ca´c oáng đn6.c sn´ du.ng trong phe´p
đo cho 3 oáng dn6ng tính, cho.n đoˆ pha loa˜ng thaáp nhaát co´ ít nhaát 1 oáng dn6ng tính va`
2 oáng co´ đoˆ pha loa˜ng cao h6n lie“n ke“ (ví du. i) 20